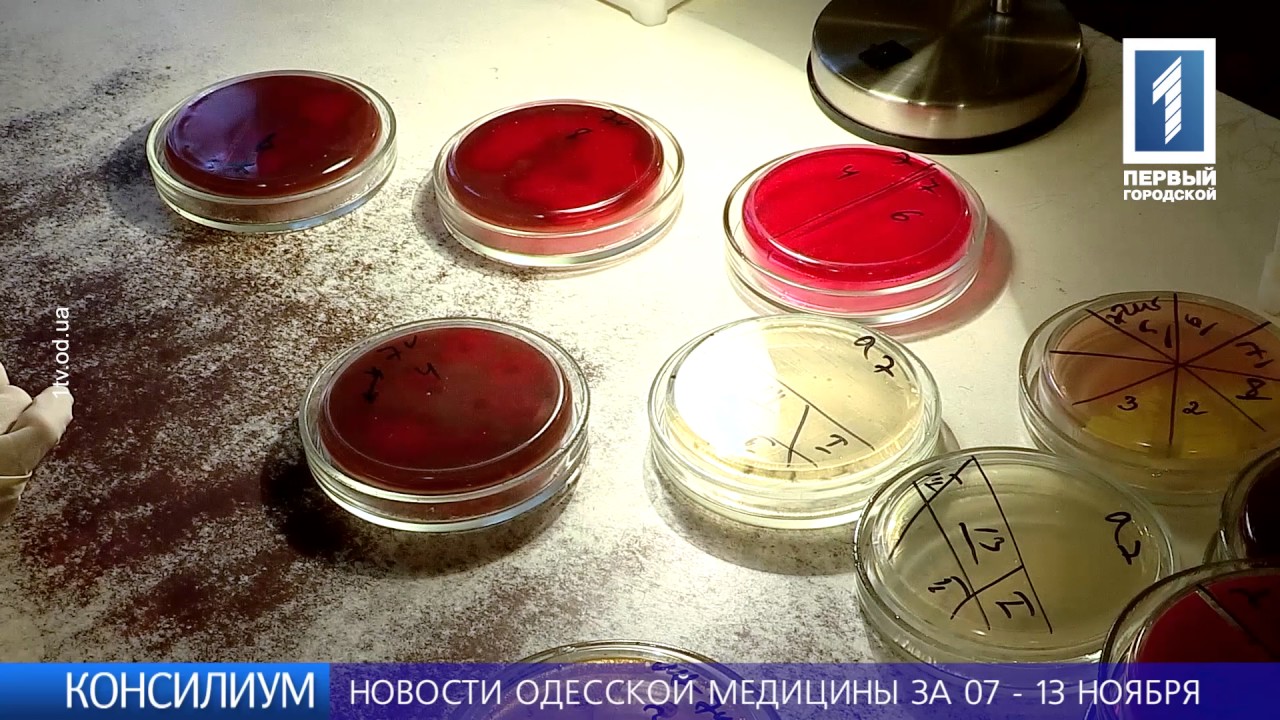
Выпуск от 16 ноября 2016 года

Ложноположительный анализ на сифилис: причины возникновения
Целью анализа крови на сифилис является выявление антител, которые организм мог выработать для борьбы с его возбудителем — бледной трепонемой.
Ложноположительный анализ на сифилис может быть в тех случаях, когда выработка антигенов произошла по другим причинам.
Почему возникает ложноположительная реакция на сифилис
Ложноположительный сифилис диагностируют в 10% случаев.
Так как анализ на сифилис назначается не только при появлении жалоб у больного, а при прохождении медкомиссии, перед приемом на работу, при беременности, перед госпитализацией, велик процент заражения у людей, которые даже не подозревали о наличии такого заболевания.
Чтобы исключить ошибку, необходимо убедиться в достоверности полученных результатов.
Положительные результаты на сифилис делятся на две группы: острые и хронические. Острый ложноположительный результат проявляется в течение 6 месяцев регулярного проведения анализов.
Причины:
- острые инфекционные нарушения;
- травмы;
- любая вакцинация за 1-7 дней до взятия пробы;
- острое отравление.
При наличии любого из факторов в организме активизирован процесс выработки антител, что и отражается на результатах анализов.
Если имеются хронические нарушения, тест может показывать ошибочные результатыв течение 6 и более месяцев.
Причины:
- нарушения соединительных тканей;
- любая форма туберкулеза;
- хронические нарушения работы печени;
- ВИЧ, гепатит В, С, D, и другие вирусные заболевания;
- аутоиммунные процессы в организме.
Ошибочным результат становится по причине систематической выработки неспецифических антител в ответ на одно из перечисленных нарушений.
Что делать, если выявили ложный сифилис
Чтобы определить, может ли анализ на сифилис быть ошибочным, нужно оценить наличие других факторов проявления заболевания и вероятность инфицирования.
Бледная трепонема — возбудитель заболевания, который передается половым путем через слизистые половых органов, рта и прямой кишки при контакте с инфицированным человеком. Также возможна передача инфекции от зараженной матери ребенку.
Инкубационный период, в течение которого заболевание не дает о себе знать, составляет 2-6 недель. После этого на местах возможного проникновения инфекции образуются сифилитические язвы с плотным основанием.
Через 1-2 недели увеличиваются и становятся болезненными ближайшие к месту поражения лимфатические узлы.
При постановке диагноза — сифилис ложноположительный необходимо повторно обратиться в медицинское учреждение. При этом сообщите о всех препаратах, которые вы принимали накануне анализа, хронических и острых заболеваниях.
Если имел место незащищенный секс с непроверенным партнером или вы обнаружили первые признаки заболевания, стоит сообщить об этом врачу.
После сбора анамнеза и проведения осмотра врач назначит вам ряд анализов, которые позволят с погрешностью менее 1% установить точный результат.
Виды тестов на сифилис
Анализы бывают двух видов: нетрепонемные и трепонемные. Первый вариант предполагает использование искусственных аналогов бледной трепонемы, во втором случае используются реальные трепонемы.
Нетрепонемные методы
Такие методики имеют широкое распространение и чаще всего используются в проведении рядовых медицинских осмотров.
Преимуществом является низкая стоимость, быстрый результат, возможность проведения исследований на стандартном лабораторном оборудовании.
Анализ на RW
Для его проведения у пациента берут кровь, реже — спинномозговую жидкость. Кровь может быть взята из пальца или вены. Погрешность при проведении такого исследования может составить до 7%.
Микрореакция преципитации (МР или РМП)
Может включать два вида тестов на сифилис RPR и VDRL. В результате распада клеток под воздействием трепонемы образуются антилипидные антитела.

Липиды могут разрушиться под влиянием других нарушений, поэтому степень погрешности при проведении ВДРЛ и РПР составляет 1-3%.
Трепонемные тесты
Такие исследования проводятся не во всех клиниках и требуют наличия дорогостоящего оборудования.
Поэтому они используются при подозрении на наличие заболевания по результатам нетрепонемных тестов. Погрешность таких исследований составляет менее 1%.
РИФ
Позволяет определить антигены и антитела. Для определения результата пациент сдает кровь из пальца или вены. В результате тестирование также позволяет установить стадию заболевания.
РПГА
Анализ на сифилис РПГА позволяет определить процент склеивания эритроцитов. Точный результат реакции пассивной гемагглютинации можно получить на 28 день после инфицирования.
ИФА
Иммуноферментное оценивание определяет наличие и стадию заболевания по уровню иммуноглобулинов различных типов.
ИФА на сифилис положительный позволяет определить типы иммуноглобулинов, которые формируются после инфицирования в течение 14 дней, 14-28 дней, более 28 дней.
ПЦР
Самый точный тест, позволяющий выявить патогенные ДНК. Он используется в редких случаях, так как требует наличия сложных реактивов.
Вероятность погрешности тестов РИФ, РПГА, ИФА составляет менее 1%. При ПЦР погрешность может составить 0-1%.
Положительный результат на сифилис у беременных
У беременных ошибочный результат может наблюдаться в 1,5% случаев при проведении нетрепонемных тестов. Анализ на данный вид заболевания является обязательным в течение всей беременности.
Первый тест на сифилис проводят в 12 недель, потом — в 30 недель и перед родами. Результат может быть ложным по причине естественных изменений организма, а в частности, иммунитета для защиты растущего плода.
Поэтому при беременности может быть назначен повторный тест, нередко он назначается даже при отрицательных результатах первого, если имел место фактор риска.
Также могут быть назначены трепонемные тесты, так как воздействие заболевания на организм ребенка более губительно, чем лечение антибиотиками в случае подтверждения диагноза.
Слабоположительный анализ
Если в полученном вами бланке с результатом стоит 1-2 плюса, это может говорить о наличии небольшого количества антител. Такие результаты могут проявиться в нескольких случаях:
- незавершившийся инкубационный период;
- поздняя форма, спустя 2-4 года;
- остаточные антитела после излечения заболевания.
В таком случае в обязательном порядке назначается повторная проверка через 2 недели.
Как правильно готовиться к анализам
Если был произведен ошибочный анализ на сифилис, вам будет назначен повторный. Чтобы его результаты были максимально точными, необходимо правильно подготовиться.
Правила:
- перед анализом разрешается пить только воду, принимать пищу запрещено;
- за сутки откажитесь от алкоголя и от курения за 1 час;
- если вы сдаете кровь из вены, проведите перед этим в состоянии покоя 10 мин;
- если обострились инфекционные заболевания, проходит менструация или пациент накануне подвергался рентгеновскому облучению, анализ крови на сифилис не проводят.
Также в списке противопоказаний находится ряд препаратов, поэтому если вы проходите лечение, сообщите о принимаемых лекарствах врачу.
Если заболевание подтвердилось
Если после проведения нескольких проверок, в том числе трепонемных, результат оказался положительным, стоит принять ряд мер:
- сообщите об этом половому партнеру, необходимо, чтобы он так же прошел обследование;
- близкие родственники должны пройти обследование;
- необходимо провести превентивное лечение близких;
- в течение всего курса лечения необходимо оформить больничный лист и избегать близкого контакта с другими людьми во избежание передачи инфекции;
- по окончании лечения выдается справка, которую нужно прикрепить к медицинской карте и предоставлять при проведении обследований на антитела, чтобы у диагностов не возникало вопросов о появлении антигенов в результатах.
При постановке диагноза информация является конфиденциальной. Она не разглашается при взятии больничного, во всех документах, которые выдаются больницей, название заболевания зашифровано, людям, не имеющим близкого контакта с больным, о постановке данного диагноза не сообщают.
После прохождения лечения пациент полностью безопасен, наличие сифилиса в прошлом не может стать причиной отказа в трудоустройстве или в реализации других прав человека.
Если диагноз подтверждается на ранних стадиях, то вероятность полного излечения составляет 100%. Бледная трепонема одна из немногих за много лет лечения больных пенициллином не выработала к нему защиты.
Поэтому лечение больных проводится при помощи препаратов на основе производных пенициллина. Если имеет место первичная форма заболевания, необходимо провести диагностику и лечение всех половых партнеров, которые были у инфицированного человека в течение 3 месяцев.
Сифилис после лечения начальной стадии не оставляет осложнений. Болезнь может привести к инвалидности, если проходило хроническое течение или имело место инфицирование в материнской утробе.
Источник:
Можно ли проходить обследования и сдавать анализы без назначения врача?
В последнее время все острее становится проблема бесконтрольного и зачастую ненужного медицинского обследования без назначения врача. Чем она вызвана — наличием открытой, порой бесцензурной информации в Интернете или доступностью разных видов обследований?
На это есть как минимум три причины
Причина 1. В поликлинике крайне трудно попасть к специалисту, в том числе к неврологу. Поэтому пациенты сначала идут на всевозможные исследования, считая, что принеся результаты доктору, они упростят ему задачу постановки точного диагноза.
Причина 2. Цена повторного приема. Многие считают, что если придут на первичный прием, доктор наверняка не назначит лечение сразу, а все равно отправит обследоваться.
И потом им придется снова платить за повторный прием и какое–то время ходить без лечения.
А ведь хороший специалист способен прокомментировать и по электронной почте результаты обследований, которые он назначил.
Причина 3. Доступ к Интернету, где можно найти минимум 10 «пугалок» на каждый симптом: «Голова кружится — у вас опухоль!» или «Помните Фриске? Срочно делайте МРТ!» А если еще и головная боль, то в купе с другими симптомами, можно себя заживо похоронить.
Конечно, распространенность гибели от онкологических заболеваний достигает 30% — это очень много, что заставляет быть настороже. Поэтому при постановке диагноза действовать необходимо правильно и врачу, и пациенту.
Будучи еще студентами медицинского ВУЗа, будущие врачи первым делом обучаются правильной постановке диагноза.
А назначение лечения — это уже отдельная тема. Если в учебной истории болезни студента в первых строках стоит МРТ — это сразу «неуд».
Как не нужно делать
Пациенту — идти на всевозможные обследования без назначения врача. Доктору — назначать дополнительные обследования без подробного расспроса пациента.
Как правильно
Самое главное — это четкая последовательность действий от простого к сложному. Сначала необходимо идти к врачу. Он подробно опросит о жалобах и истории их появления. Далее — расспрос о наличии хронических заболеваний у самого пациента и его родственников.
После идет тщательный осмотр и анализ всех симптомов. И только потом при надобности врачом могут назначаться дополнительные методы обследования, которые действительно необходимы конкретному пациенту.
Кроме того, хороший врач при подробном расспросе и осмотре в 90% случаев может сразу поставить точный диагноз и обойтись совсем без дополнительного обследования.
Обследование — это не только УЗИ, рентген, КТ, МРТ и другие аббревиатуры.
Те же, например, анализы крови, которые начинают с обычного общего анализа, а затем уже могут назначаться специфические — на уровень тех или иных гормонов, белков, ферментов.

В любом случае вам не нужно думать, как обследоваться перед приемом врача. Просто выберите специалиста — он подумает за вас.
Почему так? Потому что только врач может определить, какие симптомы свойственны тому или иному заболеванию и уже назначить обследование.
Дополнительные методы обследования помогают специалисту лишь уточнить диагноз, но никак не установить его сразу. К тому же лишние анализы могут иметь опасные побочные эффекты.
Важно.
Такие симптомы, как, например, головная боль, головокружение, шум в голове, ушах, снижение памяти — редко являются признаком опухоли или требуют проведения дорогостоящих обследований типа МРТ.
Поэтому прежде чем бежать на многочисленные анализы, снимки различных отделов позвоночника и не только, помните, вы можете не только потратить время и деньги впустую, но и заработать новые болячки.
.
Случай из практики медицинского центра «Доктрина»
Пациент: мужчина, 35 лет
Жалобы: повышение температуры до 37,0–37,5⁰C
Что сделал пациент. Почитав информацию в Интернете, решил обследоваться сам. Сдал ревмопробы (маркеры аутоиммунных, системных, заболеваний). Затем пошел к ревматологу — ревматические заболевания были исключены. После сдал иммунный статус, пошел к иммунологу — нарушений работы иммунитета не установлено.
Далее сдал кровь на онкомаркеры, часть из них были на границе с нормой, ушел к онкологу — онкологические заболевания не выявлены.
Наконец пришел к терапевту.
При осмотре доктором было выявлено увеличение размеров щитовидной железы и назначено следующее: анализ крови на гормоны щитовидной железы (ТТГ, Т4, АТ-ТПО), УЗИ щитовидной, консультация эндокринолога.
Результат: диагноз — диффузный токсический зоб, гипертиреоз. В настоящее время проводится лечение.
Потрачено: от 19 500 рублей в первом случае (включая вышеперечисленные самостоятельные обследования). Во втором — 3 920 рублей (включая консультацию и обследования по назначению врача). Разница заметна.
ИМЕЮТСЯ ПРОТИВОПОКАЗАНИЯ
НЕОБХОДИМА КОНСУЛЬТАЦИЯ СПЕЦИАЛИСТА
Анастасия Владимировна Власенко Врач–невролог, цефалголог, главный врач МЦ «Доктрина»
Где сделать?
Что Консультация невролога, УЗИ, ЭКГ, все виды лабораторных исследований
Где Медицинский центр «Доктрина»
Адреса в Екатеринбурге пр. Космонавтов, 31/а, оф. 313, ТЦ «Меркурий»
Телефон +7 (343) 372-44-96
Сайт mc-doctrina.ru
.com/mc_doctrina
Источник:
Анализы на сифилис после лечения: когда становится отрицательным
Анализы на сифилис сдают не только при обследовании, но и после лечения заболевания для оценки эффективности препаратов.
После того, как больной пройдет курс антибактериальной терапии, он еще в течение некоторого времени остается под наблюдением врача-венеролога.
Продолжительность клинико-серологического контроля различается и составляет:
- 6 месяцев — после превентивной терапии
- 3 года – при первичном серопозитивном сифилисе и при вторичной форме заболевания
- 5 лет – после терапии третичного сифилиса
Клинико-серологический контроль включает осмотр венеролога и регулярные лабораторные исследования крови на сифилис.
Заболевание зачастую может протекать бессимптомно.
При несоблюдении рекомендаций лечащего врача в период курса терапии или если патоген оказался резистентным в отношении определенной группы лекарств, то случается рецидив.

По этой причине пациент должен после лечения еще некоторое время сдавать анализы.
Первое исследование на сифилис проводится через месяц после приема последней дозы антибиотика.
Какие сдают анализы после лечения сифилиса
После того, как пройден курс лечения сифилиса, больной должен сдать анализ, чтобы врач мог дать оценку проведенной терапии.
Самым распространенным видом контрольных исследований являются серологические тесты.
Доктор может получить информацию не только о наличии или отсутствии антител, но и узнать какие иммуноглобулины присутствуют на данном этапе процесса.
По типу антител врач может судить о стадии протекания заболевания.
Основной вид исследования – RPR или антикардиолипиновый тест.
Суть исследования в том, что при добавлении к сыворотке крови кардиолипинового антигена в ней должен образоваться темный осадок.
Такое возможно при наличии в биоматериале Ig M.
С помощью RPR определяют, имеются ли антитела к липоидам возбудителя сифилиса.
Данный вид диагностики является одним из самых надежных способов выяснить, правильно ли подобраны лекарства.
При понижении в кровяной сыворотке концентрации патогенов происходит уменьшение количества антител.
При снижении концентрации АТ, как минимум, в 4 раза, можно говорить об эффективности проводимого лечения.
Пациент будет сдавать анализы до тех пор, пока результат не станет отрицательным.
Если два теста следующих подряд в течение шести месяцев покажут, что антитела отсутствуют, то данный факт будет служить критерием выздоровления пациента.
Для анализа берут кровь из вены.
Чтобы получить достоверные результаты пациент должен придерживаться определенных правил:
- явиться в лабораторию с утра для сдачи крови натощак
- накануне не рекомендуется употреблять жирные продукты и принимать алкоголь
- исключить курение, как минимум, на один час до сдачи крови
Если у пациента имеются сопутствующие инфекции, то их наличие может сказаться на результатах исследования.
Поэтому будет правильно, если пациент заранее предупредит доктора о наличии проблем со здоровьем и приеме лекарственных средств.
Могут ли не проходить следы сифилиса после лечения
После правильно выбранного курса лечения титр АТ начнет снижаться.
Для отслеживания эффективности терапии могут использоваться, как трепонемные, так и нетрепонемные серологические реакции.
Результаты таких анализов еще долго после окончания лечебного курса остаются положительными.
В случае, когда для контроля используются нетрепонемные тесты, то после окончания лечения, результаты исследований должны быть отрицательными.
В таком случае пациента могут снять с учета.
Если анализ на сифилис после окончания курса сомнительный, то проводится более глубокое обследование.
Используется методика более высокоточная методика — ПЦР, которая позволяет выявить не наличие АТ, а фрагменты ДНК бледной трепонемы.
Если генетический материал в исследуемом биоматериале отсутствует, то это свидетельствует об отрицательном результате.
Может ли анализ показать положительный результат после лечения сифилиса
По окончании лечения большая часть пациентов считает, что контрольные анализы будут отрицательными.
На первый взгляд – все логично.
Раз микроорганизмы уничтожены, значит, возбудитель в крови отсутствует, а, следовательно, анализ на сифилис не должен быть положительный после лечения.
Но, часто бывает наоборот.
Происходит так, если в крови возбудителя нет, но иммуноглобулины остались.
Даже, если его в крови больше нет, то антитела не могут сразу же исчезнуть.
Иммуноглобулины еще долго будут оставаться в организме: от нескольких месяцев до нескольких лет, в зависимости от формы патологии.
Какие выводы может сделать врач об эффективности лечения, если результаты серологических реакций остаются положительные?
Бывает, что положительные результаты тестов могут сохраняться всю жизнь.
Результаты анализов могут выдаваться либо с показаниями титра антител, либо в заключении указывается результат, показывающий определенную степень градации: слабоположительный, положительный или сомнительный.
Врач интерпретирует результат анализа не только по наличию антител, но и оценивает динамику изменения их количественного состава.
Если через несколько месяцев титр АТ поменяется в сторону уменьшения, то это указывает на излечение.
Но, до тех пор, пока антитела в крови, пациент будет продолжать регулярно сдавать кровь на анализ.
Если снижение титра АТ не происходит или же присутствует тенденция к увеличению, то это указывает на то, что заболевание не вылечено, и возбудитель еще остается в организме.
При сохранении положительных серологических реакций и отсутствии снижения титра АТ на протяжении года после прохождения лечебного курса, пациента считают серорезистентным.
Больной не признается таковым, если анализ по-прежнему положительный, но титр АТ падает.
Позитивный прогноз наблюдается, когда:
- реакция на сифилис станет слабоположительной
- титр АТ снизится более, чем в четыре раза, в сравнении с первоначальным
Такие результаты свидетельствуют о замедлении негативизации серологических реакций, и пациент подлежит дальнейшему наблюдению.
Неважно, насколько быстро они негативируются, повторные анализы пациенту назначают сдать через полгода.
Доктор смотрит, как меняются результаты исследований: присутствует ли динамика в сторону спада титра антител.
При наличии отрицательной реакции или если имеется тенденция в снижении концентрации антител, то это является критерием излеченности пациента.
В любом из случаев всегда сохраняется риск развития рецидива.
Поэтому пациент еще будет некоторое время состоять на учете у венеролога.
Когда реакция на сифилис остается положительной, но при этом титр АТ изменяется в сторону уменьшения, то спустя полгода пациент вновь сдает тесты.
Отрицательные реакции свидетельствуют о том, что пациент здоров.
Если же титр иммуноглобулинов остается неизменным и больше не снижается, то назначается еще один курс приема антибиотиков.
Если заболевание было запущено, то по окончании лечения пациент будет находиться под наблюдением венеролога в течение трех лет.
Может ли анализ показать рост титра антител после лечения сифилиса
После лечения заболевания, если оно проводилось современными антибиотиками и при выполнении больным всех предписаний врача, титры иммуноглобулинов не должны возрастать.
Когда анализы показывают рост иммуноглобулинов или их титр не падает даже после проведенного лечения, то это значит, что болезнь не вылечена.
Иммунитет продолжает борьбу с патогенами, вырабатывая иммуноглобулины.
Если так случилось, то немедленно проводится повторная антибактериальная терапия.
Если через некоторое время после приема антибиотиков наблюдается рост антител, то также будет проведен еще один терапевтический курс.
Могут назначаться сразу несколько групп антибиотиков, причем в самых высоких дозировках.
Лечат таких больных традиционно стационарно, но возможно и в поликлинических условиях.
Может ли перейти сифилис на окружающих после лечения
Если пациент успешно пролечился и отсутствуют клинические проявления заболевания, то он не является заразным, даже если контрольные анализы показали положительные результаты.
Серологические реакции на протяжении некоторого времени еще могут давать положительный результат.
Это не опасно, если титр иммуноглобулинов начинает постепенно уменьшаться.
Возбудитель еще может присутствовать в крови, но вероятность заражения детей или партнера по окончании лечения ничтожно мала.
Передача инфекции возможна только если имеется выделение трепонем больным.
Это возможно при наличии твердого шанкра на гениталиях или высыпаний на теле, что характерно для первичного и вторичного сифилиса.

Если внешних проявлений нет, то инфицирование окружающих маловероятно.
Могут ли быть анализы крови на АТ отрицательные, если есть сифилис
После антибактериального курса лечения серологические реакции еще некоторое время остаются положительными, что не является показателем того, что пациент болен.
Случается, что больной сифилисом человек сдает анализ крови и получает отрицательные результаты.
Такое возможно в самом начале заболевания, когда еще в организме не образовались антитела.
Что показывают анализы, если пролечился и снова заразился?
В таком случае результат будет оставаться положительным, но при этом титр антител будет нарастать.
Если по результатами серологических исследований выяснится, что сифилис активировался, будет проведен еще один курс антибактериального лечения с применением препаратов в более высоких дозах.
Может ли анализ на инфицирование сифилисом через много лет после лечения стать положительным
По окончании курса терапии, как только все контрольные анализы покажут, что инфекции больше нет, пациента снимают с учета.
С чем может быть связано, что через много лет, пациент проходит обследование, и результаты на сифилис оказываются положительными?
Одной из причин может быть: повторное инфицирование или ложноотрицательные результаты.
- После перенесенного однажды заболевания, у человека не развивается иммунитет к бледной трепонеме. При этом не исключается повторное инфицирование. Чаще всего источником инфекции выступает тот же половой партнер, что и в прежнем случае. Поэтому диагностику и лечение должны проходить оба партнера, а если их больше, то все.
- Если человек проходит обследование, при котором используются нетрепонемные тесты (РМП, RPR), то возможна выдача ложноотрицательного результата.
Некоторые заболевания могут дать положительную реакцию.
Среди них: онкологические процессы, инфекции и др. патологии.
При получении результата анализа, указывающего на наличие положительной реакции, следует сдать подтверждающие анализы.
Если они подтвердят наличие заболевания, то пациенту будет предложено пройти дополнительный терапевтический курс.
Диагностика сифилиса у младенцев
Если женщина решила зачать ребенка после того, как прошла курс лечения сифилиса, то перед беременностью ей необходимо будет сдать серологические анализы, чтобы исключить заболевание.
При подтверждении диагноза будет проведен курс лечения, чтобы подготовить женщину к рождению здорового младенца.
После рождения малыша за ним будут наблюдать.
Первое обследование будет проведено, когда ребенку исполнится три месяца.
Малыш будет осмотрен педиатром, ЛОР врачом, неврологом и офтальмологом.
Также будет взята кровь на анализ.
- При отрицательном результате плановый осмотр будет проведен в годовалом возрасте. Если повторный тест также будет отрицательным, то малыш будет снят с учета.
- При положительном серологическом тесте в 3 месяца, повторный будет, когда ребенку исполнится полгода, а затем – в 1 год.
- В случае болезни малыша и после лечения график контроля результатов анализов совпадает с таковым у взрослых. Разница в том, что продолжительность наблюдения за состоянием малыша составляет не менее года.
Если контрольные исследования показали положительный результат, то потребуется:
- сделать подтверждающий анализ
- пройти осмотр у разных специалистов, чтобы они подтвердили или опровергли наличие симптомов заболевания
- проверить на наличие трепонем в спинномозговой жидкости
При подтверждении диагноза ребенок будет получать специфическое лечение.
Если анализы не показывают наличие возбудителя ииммуноглобулинов, то потребуется пройти повторную диагностику через три месяца.
Лечение сифилиса: что потом
После прохождения курса терапии каждый пациент находится под наблюдением венеролога от трех месяцев до 3-х лет.

В случае, когда первый курс приема антибиотиков не дал позитивного результата, то срок избавления от недуга удлиняется, так как больного будут лечить повторно.
Что такое и зачем нужен центр снятия с учета пациентов, переболевших сифилисом?
В Москве, где снимают с учета больных сифилисом, потребуется:
- пройти серологические тесты
- посетить различных специалистов
На основании полученных результатов исследований и заключений специалистов, пациенту дадут справку, в которой подтвердят, что пациент нуждается в лечении заболевания.
После проведенного курса терапии выдадут документ, подтверждающий, что пациент выздоровел.
Справка по серологическим анализам, полученная от сифилидолога, о том, что пациент больше не нуждается в лечении патологии, дает право человеку устроиться на любую работу.
Такую же справку дадут беременной женщине, где будет указано, что на учете она не состоит.
Для сдачи анализов после лечения сифилисаобращайтесь к автору этой статьи – венерологу в Москве с многолетним опытом работы.
Источник:
Прием гинеколога по результатам анализов
Чтобы выяснить состояние своего здоровья, женщинам приходится сдавать разнообразные анализы. После проведения диагностики у больной на руках оказывается множество бланков с результатами, разобраться в которых самостоятельно нереально.
Для этого требуются определенные знания и опыт, поэтому нужно обратиться к врачу-гинекологу Университетской клиники. Специалист выявит имеющиеся отклонения от нормы, объяснит их причину и назначит лечение.
Как проходит консультация гинеколога по результатам анализов
Врач оценивает полученные показатели и по их результатам назначает лечение. Для уточнения диагноза гинеколог может направить женщину на дополнительные диагностические процедуры или на консультацию к другим специалистам.
В этом случае врача можно будет посетить дважды – сразу после сдачи анализов и после дополнительной диагностики. Проводимые обследования и лечение зависят от обнаруженных отклонений от нормы.
Общий анализ крови показывает признаки воспаления, в том числе в женских половых органах, и анемию (малокровие), возникающую при маточных кровотечениях. Таким женщинам нужно пройти УЗИ малого таза, а иногда и гистероскопию (осмотр внутренней поверхности матки).
Общий анализ мочи. Появление в урине крови и гноя часто возникает при переходе воспалительных процессов с половой сферы на соседние органы. Такой пациентке нужна консультация уролога, который выяснит, не поразила ли инфекция мочеточники и почки.
Мазок на флору с микроскопией. Для этого анализа образцы, взятые из половых путей и мочеиспускательного канала, окрашивают и осматривают под микроскопом. Метод выявляет различные инфекции, в том числе ЗППП. При обнаружении патогенных микроорганизмов назначается антибактериальная терапия.
Анализ на скрытые инфекции методом ПЦР обнаруживает самых разных возбудителей ЗППП, в том числе тех, которые не выявляются в мазке. Обследование показывает разросшуюся условно-патогенную флору – грибок молочницы, гарднереллу. В таких случаях женщине назначают антибактериальные, антипротозойные и антигрибковые препараты.
Фемофлор – современный вариант ПЦР-анализа, выявляющий сразу несколько типов возбудителей. В зависимости от цели обследования и имеющихся жалоб, можно выбрать одно из исследований, выявляющих от 4 до 16 показателей флоры. При наличии отклонений от нормы и выявлении ЗППП пациентке назначается лечение с последующей повторной сдачей анализа.
Анализ на цитологию выявляет предраковые и раковые клетки. Это обследование назначают при дисплазии – заболевании шейки матки, на которой появляются светлые пятна измененной слизистой.
Болезнь вызывается папилломавирусом, который обнаруживается в ПЦР-анализе. Такой пациентке проводится удаление патологических очагов на шейке с помощью лазера или радионожа.
Параллельно назначаются препараты для уничтожения вируса.
Анализы на гормоны сдаются женщинами, страдающими гормональными сбоями. У пациенток наблюдаются проблемы с беременностью и нарушения менструального цикла. При гормональном сбое женщину направляют к эндокринологу, который назначит гормонозаместительную терапию.

Анализ на антимюллеров гормон проводится для выявления овариального резерва. Его сдают на стадии подготовки к беременности, чтобы выяснить репродуктивную способность женщины. При отклонениях от нормы пациентку направляют на консультацию к репродуктологу.
Стоимость услуг гинеколога в Университетской клинике
| Услуга | Цена, руб. |
| Прием (осмотр, консультация) врача-гинеколога с высшей квалификационной категорией | 1400 |
| Ультразвуковое исследование матки и придатков | 1100 |
| Взятие гинекологического мазка | 350 |
| Введение или удаление внутриматочной спирали | 1500 |
| Все цены ⇒ | |
| Все цены ⇒ |
Что делать после консультации гинеколога по результатам анализов
- Как можно быстрее пройти назначенную дополнительную диагностику, чтобы получить полную картину состояния здоровья. Если обследование растянуть на длительное время, результаты первых обследований устареют и придётся сдавать анализы заново.
- Пройти все назначенные диагностические процедуры. Чем большее количество обследований проведено, тем выше точность поставленного диагноза и эффективность лечения. Пациентка, прошедшая только часть рекомендованных диагностических мероприятий, потратит впустую время и деньги, поскольку полную картину болезни получить не удастся.
В Университетской клинике можно сдать все необходимые анализы, пройти диагностические процедуры, а также получить консультацию гинеколога по результатам анализов. В медцентре также можно вылечить обнаруженные патологии.
Такой подход удобен для пациенток, которые получают все необходимые услуги в одном медучреждении, не тратя время на поездки по городу.
Источник:
Предоперационное обследование: анализы, обследование перед госпитализацией
Предоперационное обследование — важнейший этап при подготовке к госпитализации и хирургическим вмешательствам.
Лабораторные тесты являются ценнейшим инструментом не только в диагностировании патологического состояния, но и в наблюдении за течением болезни, контролировании эффективности проводимой терапии.
Столь же важную роль играют данные лабораторной диагностики при необходимости обследования перед госпитализацией и особенно перед оперативным вмешательством. Лабораторные тесты помогают выявить возможные противопоказания к предполагаемому лечению (операции), оценить общее состояние здоровья, минимизировать риски анестезии и предотвратить осложнения.
Согласно существующим нормативам, плановая госпитализация подразумевает наличие у пациента на руках целого списка готовых анализов. И зачастую сдать все в один день, и тем более быстро получить результаты, невозможно физически.
По крайней мере, в условиях обычной поликлиники. Ведь сначала нужно записаться на прием к участковому врачу и получить направления. Сдать некоторые анализы без подготовки тоже невозможно.
Значит, мероприятие откладывается еще минимум на день.
Далее нужно отсидеть очередь в процедурный кабинет, который работает до определенного часа и ни минутой дольше. После сдачи анализов нужно дождаться результатов и забрать бланки у лечащего врача. При этом следует помнить, что у некоторых анализов весьма короткий срок действия. А поликлиники не работают по выходным…
Конечно же, при современном темпе жизни все перечисленное представляется верхом неудобства. Выход из этой ситуации сдача крови и иного биоматериала на анализ в платной клинике.
В «МедикСити» вы можете пройти весь комплекс необходимых обследований перед госпитализацией или операции в любой день и в удобное для вас время и получить результаты в момент их готовности в удобном для вас виде на руки или по электронной почте.
Подготовка к лабораторным исследованиям
После назначения необходимых анализов для госпитализации лечащий врач или медсестра информируют пациента о том, как следует готовиться этим тестам.

Большинство исследований крови полагается делать натощак, что подразумевает не только отказ от пищи, но и от питья, курения. Именно поэтому оптимальное время сдачи крови утро с 8.00 до 11.00.
Что следует знать пациенту о предоперационном лабораторном обследовании (обследовании перед госпитализацией):
Биохимические, иммунологические, гормональные, коагулологические тесты выполняются строго натощак (т.е. после 8-14 часов голодания).
Общий анализ крови, определение резус-фактора и группы крови, а также ПЦР-диагностика инфекций проводятся не ранее, чем через 3 часа после последнего приема пищи.
Накануне любого обследования желательно избегать физических нагрузок, приема алкоголя, серьезных перемен в диете и распорядке дня.
Для анализа мочи требуется утренняя моча (другие варианты оговариваются отдельно). Перед сдачей образца не следует употреблять овощи и фрукты, способные повлиять на цвет мочи (свекла, морковь). Не стоит принимать мочегонные препараты. Накануне сдачи анализа необходимо исключить спиртное, соленую и острую пищу.
Сбор мочи производится самостоятельно после тщательного туалета наружных половых органов (во избежание искусственного повышения количества эритроцитов и лейкоцитов). В одноразовый контейнер необходимо собрать среднюю порцию мочи (первая доза для анализа не подходит). Женщинам в период менструации рекомендуется повременить со сдачей анализа.
Анализы для хирургической госпитализации
Перечисленные ниже анализы являются стандартными при госпитализации в хирургическое отделение, однако пациенту следует заранее уточнить, не потребуются ли в конкретном лечебном учреждении дополнительные тесты.
Важно! При сдаче образца крови для исследования на ВИЧ-инфекцию необходимо иметь при себе паспорт (или свидетельство о рождении + паспорт родителя, в случае, если пациент не достиг совершеннолетия), поскольку в ином случае анализ оформляется как анонимный и не подходит для предъявления по месту госпитализации.
Итак, для хирургической госпитализации потребуются следующие анализы:
Биохимические исследования крови:
- Аланин-аминотрансфераза (Alanine aminotransferase);
- Аспартат-аминотрансфераза (Aspartate aminotransferase);
- Билирубин общий (Bilirubin total);
- Билирубин прямой (Bilirubin direct);
- Глюкоза (Glucose);
- Креатинин (Сreatinine);
- Мочевина (Urea);
- Общий белок (Protein total).
Гемостазиологические исследования:
- Активированное частичное тромбопластиновое время (Activated Partial Thromboplastin Time);
- Протромбин (Prothrombin), Международное нормализованное отношение, МНО (International Normalized Ratio, INR);
- Фибриноген (Fibrinogen).
Иммуногематология:
- Определение группы крови и резус-принадлежности (Blood group, ABO и Rh-factor, Rh).
Важно! В некоторых хирургических стационарах данный анализ предпочитают делать самостоятельно, поэтому уточните этот вопрос заранее.
Инфекции:
- Вирус гепатита В (Hepatitis B Virus), качественное определение поверхностного антигена;
- Вирус гепатита С (Hepatitis C Virus), качественное суммарное определение антител;
- Вирус иммунодефицита человека (Human Immunodeficiency Virus), качественное суммарное определение антител к 1 и 2 типу вируса и антигена p24 anti-HIV1,2/Ag p24;
- Возбудитель сифилиса (Treponema pallidum), антикардиолипиновый тест (RapidPlasmaReagin, RPR).
Общеклинические исследования крови:
- Общий анализ крови + СОЭ с лейкоцитарной формулой (с микроскопией мазка крови при наличии патологических сдвигов), венозная кровь.
Общеклинические исследования мочи:
- Общий анализ мочи (Urine test) с микроскопией осадка.
Также в список предоперационных обследований могут входить:
Важно! Перед оперативным вмешательством рекомендуется посетить отоларинголога, стоматолога, гинеколога для санации возможных очагов хронической инфекции. Это поможет уменьшить риск послеоперационных осложнений.
Анализы для терапевтической госпитализации
Для того, чтобы лечь в больницу на обследование или лечение, пациенту также необходимо пройти ряд лабораторных тестов для оценки общего состояния, выявления возможной аллергии или противопоказаний к препаратам и лечебным процедурам.

В зависимости от профиля отделения, требования лечебного учреждения к списку сдаваемых анализов могут варьироваться, поэтому уточнить всю необходимую информацию пациенту следует до похода в процедурный кабинет.
Что входит в стандартный список анализов для госпитализации в стационар?
Те же, что для хирургической госпитализации, а также:
Серологическая диагностика для госпитализации
Посредством серологического анализа выявляется наличие в крови пациента антител и антигенов к таким грозным заболеваниям, как ВИЧ, гепатит, бруцеллез и т.д.
Данное тестирование помогает определить форму и стадию болезни, а также контролировать успешность терапии.
В серологическое исследование крови входят следующие тесты:
Срок действия анализов для госпитализации
Все исследования, которые пациент проходит перед тем, как лечь в больницу, должны быть максимально свежими, дабы текущее состояние его здоровья было отражено в полной мере.
Поэтому затягивать с госпитализацией после получения всех результатов на руки не следует. Если какой-либо из имеющихся анализов устарел, пациент не допускается к операции /госпитализации. В этом случае необходимо повторно сдать образцы.
Срок годности лабораторных анализов:
- клинический (общий) анализ крови 7-10 дней;
- биохимический анализ крови 10-30 дней;
- анализ крови на сахар 7-10 дней;
- коагулограмма 1 месяц;
- тест на ВИЧ 3-6 месяцев, в зависимости от требований стационара;
- экспресс-диагностика на сифилис (реакция Вассермана) 3-6 месяцев;
- анализ крови на маркеры вирусных гепатитов групп В, С, D, E
- до 3-6 месяцев;
- анализ на грибковые и паразитарные инфекции до 6 месяцев;
- клинический анализ мочи 7-10 дней;
- группа крови и резус-фактор бессрочно.
В многопрофильной клинике «МедикСити» вы можете сдать все необходимые анализы и пройти все нужные обследования в удобное время, без очередей и стресса.
Мы заботимся о вашем здоровье и ценим ваше время!
Источник:



